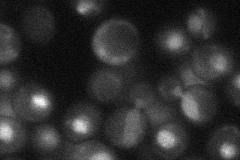
YIR008C

View description
Subunit of DNA primase, which is required for DNA synthesis and double-strand break repair
Localization:
Intensity:
Fold change:
Significance:
-
C’ GFP library in SD

nucleus26.1 -
N' NOP1pr-GFP in SD

cytosol,nucleus97.4968 -
N' TEF2pr-mCherry in SD

nucleus175.164 -
N' NATIVEpr-GFP in SD
nucleus34.3023 -
N' TEF2pr-VC and Cyto-VN in SD

nucleus58.2042 -
C’ GFP library in SD+DTT

nucleus22.270.85No -
C’ GFP library in SD+H2O2

nucleus28.181.07No -
C’ GFP library in Starvation Media

nucleus23.80.91No -
C’ GFP library on the background of Pup2-DaMP

nucleus -
C’ GFP library on the background of CCT mutant

nucleus26.22531.00453No
